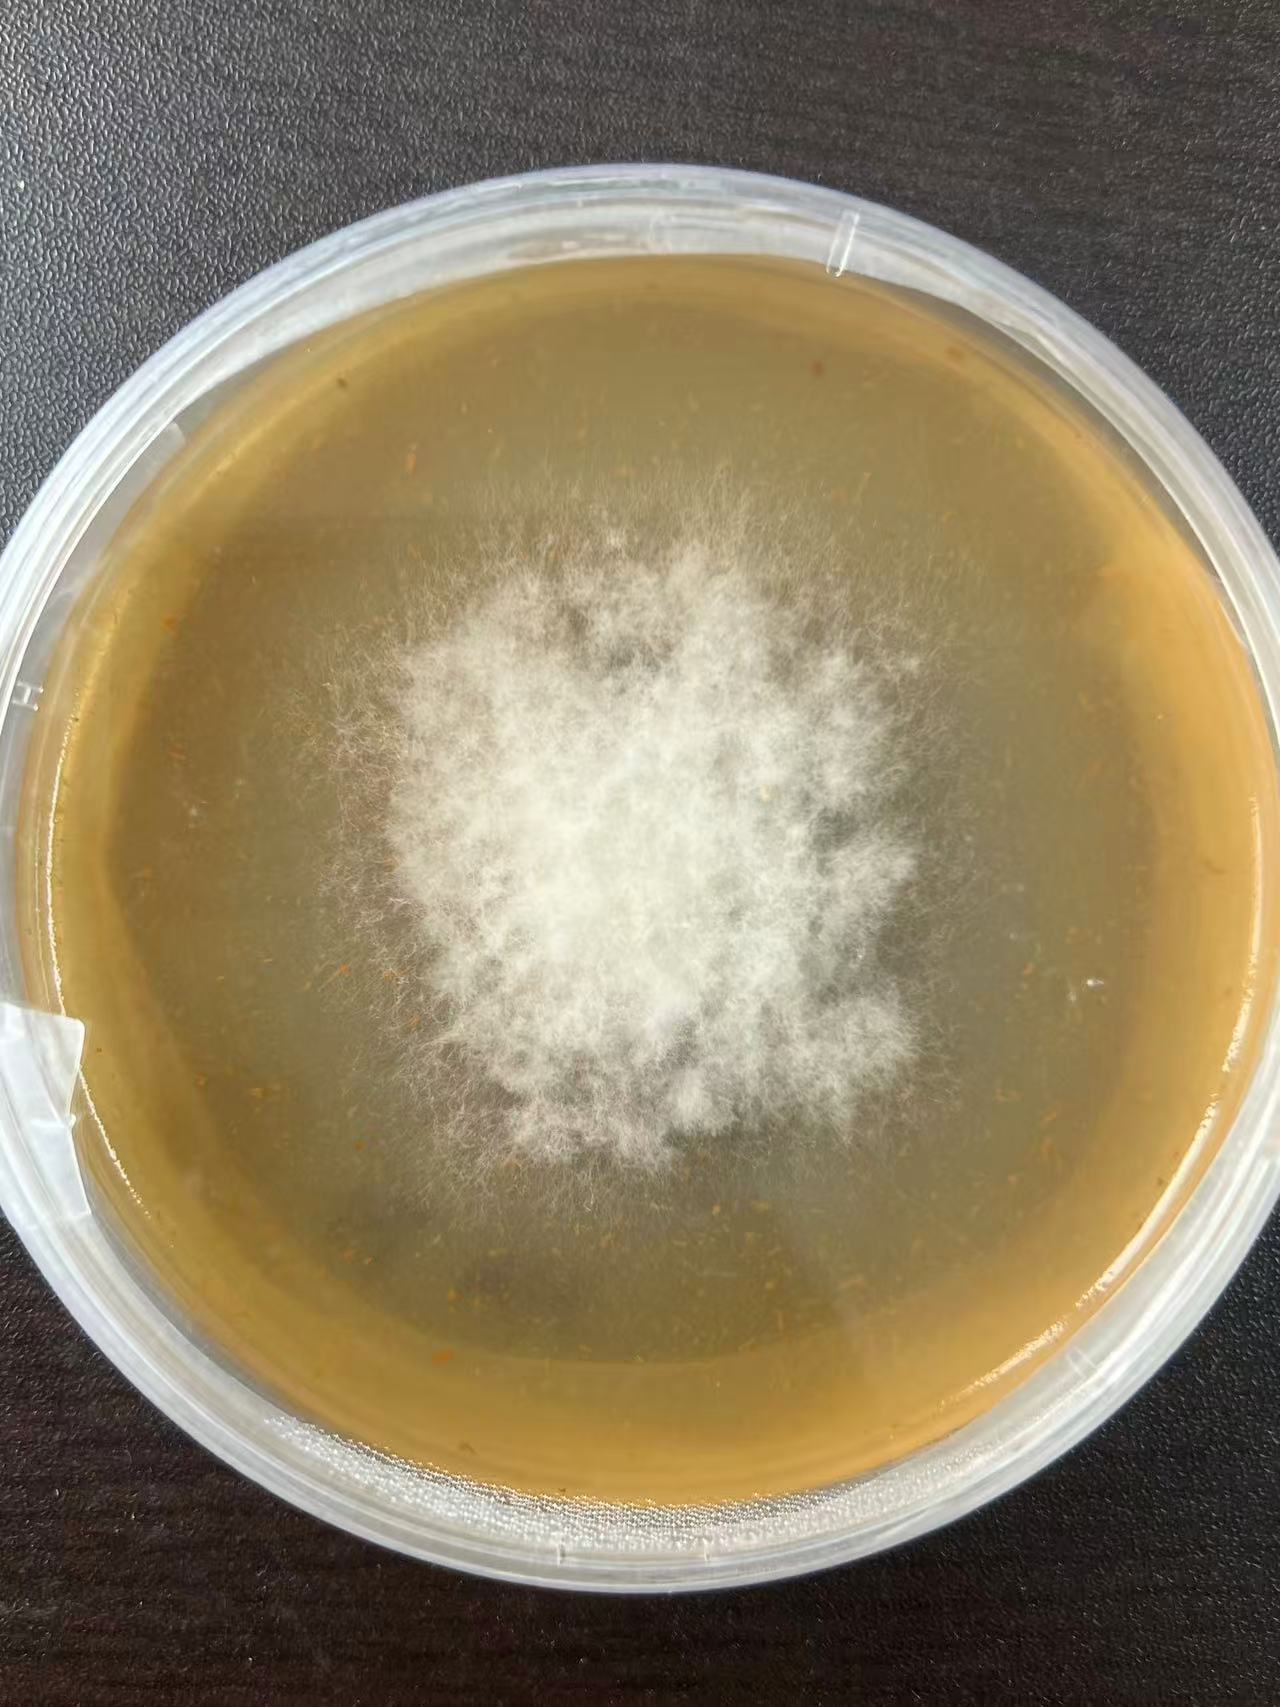

1、蔬菜研究所科技人员进行韭菜灰霉病病原菌的分离纯化培养工作,明确当地韭菜灰霉病致病菌群,填补区域病害病原基础数据空白,为韭菜灰霉病致病机理研究提供核心试验材料;避免盲目用药,减少农药残留;助力绿色防控研发及抗病韭菜品种筛选。

2、完成院里交办的其他工作。
1、蔬菜研究所科技人员进行韭菜灰霉病病原菌的分离纯化培养工作,明确当地韭菜灰霉病致病菌群,填补区域病害病原基础数据空白,为韭菜灰霉病致病机理研究提供核心试验材料;避免盲目用药,减少农药残留;助力绿色防控研发及抗病韭菜品种筛选。
2、完成院里交办的其他工作。